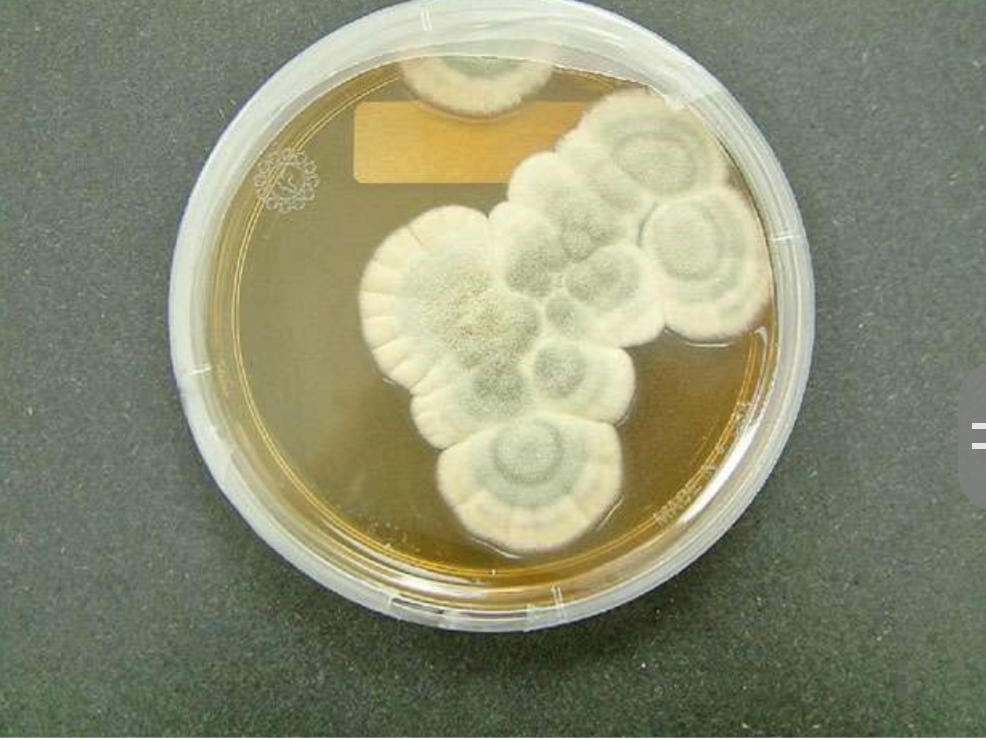

History of Antibiotics How a mistake saved lives

Even though the word ‘antibiotics’ wasn’t invented until less than a century ago, the use of substances with antibiotic properties has a much longer history. For an example, it’s said that in preparing for battle, the army of King Dutugamunu, famous Sri Lankan King who ruled during Anuradhapura era, used to prepare Kevum (Oil cakes) months in advance and keep them exposed to air so the mould can grow on them. Later, they were used to prepare a poultice to apply on battle wounds to prevent them from festering.
The exact timing of the discovery of antibiotics is a bit controversial, because various scientists during various time periods discovered substances that could kill bacteria. But the discovery of penicillin; the very first synthetic antibiotic substance which is widely used even today, has an interesting story behind it.
From ‘mistake to cure’
Sir Alexander Fleming was an army physician and a renowned researcher who had made significant contributions to the medical community in the early 1900’s. He was conducting yet another research on his lab on a bacterial type called Staphylococci.
Even though he was a distinguished scientist, he wasn’t known for his tidiness. One day, in 1928, he stacked all his petridishes which contained the cultures of bacteria on a bench at a corner of the lab, before going on holiday with his family. Upon returning, he wasn’t surprised8 to see one culture was contaminated by a common fungus (mould), effectively ruining it’s value for the experiment.
But he was intrigued to see that the bacteria colonies surrounding the area of invasion by the fungus have been destroyed. He isolated the mould and grew it separately, experimenting and discovering that the fungus, named Penicillium notatum, effectively killed many bacteria, even at lower doses.
This discovery effectively changed the history of medicine, because it triggered not only the isolation and mass production of penicillin, but also inspired and provided guidance in the discovery of numerous other antibiotics which save the lives of millions of humans as well as animals each day.It is difficult to imagine that all this happened thanks to an accident, isn’t it?
Imagine how different the world might be today, if Fleming threw that culture away, as another failed experiment! Some of us even may not be alive, because without antibiotics, a disease like pneumonia or a wound infection may have killed our parents or grandparents at a young age. Therefore, take Sir Fleming as an example.
Every time you are ready to cast aside an experience, a thought, a person, as a failure, look again with a different view, because that may have the power to open up a wonderful new pathway for your life.
About Antibiotic Resistance
But why do we need different antibiotics to treat different diseases? Just as we as humans are different from other animals in various ways, so are disease causing micro organisms. They prefer different parts of the body and have their own individual weaknesses. Therefore different antibiotics use different strategies to attack microbes.
Even this sounds like great news, doesn’t it? If we can use different antibiotics for different pathogens, and if we use them regularly, we can sweep them off the face of earth, right?
Wrong. Two factors stand against us. One, Mother Nature doesn’t take a side. Just as she gave us antibiotics which will help our species survive longer, she gave antibiotics the ability to evolve, causing antibiotic resistance. In every sample of bacteria which respond to a certain antibiotic, there are a few ‘different’ ones which have mechanisms that can withstand the effect of antibiotics. When exposed to antibiotics unnecessarily and for prolonged periods, these resistant bacteria survive and reproduce. They are then spread to other carriers causing disease, especially in environments like hospitals.
Since these new ‘super species’ now do not respond to the previous group of antibiotics, we have to treat these patients with stronger antibiotics which can go past the defenses of the new species. Methicillin-res istant Staphylococcus aureus (MRSA), Vancomycin Resistant Enterococci (VRE) and Multi-Drug Resistant Tuberculosis (MDR TB) are some such super-species.
This brings us to our second problem with antibiotics. Even though the resistance to the limited classes of antibiotics is rapidly increasing, the discovery of new antibiotics happens at a very slow rate. It’s said that there are only six new classes of antibiotics which were discovered after 1960’s and all of them act only against a limited group of microbes.
Even though we are focusing mainly on anti-bacterial agents in this article, these facts are true for anti-fungal and anti-viral agents as well.
The end of ‘Golden era’ nears

You and I were fortunate enough to be born in what is referred to as the ‘Golden Era of Antibiotics’. This meant that we could fight through infections that killed or crippled our ancestors, like Tuberculosis, Leprosy, which accounted for 30% of deaths in the Pre- antibiotic era. But this era is rapidly declining due to antibiotic resistance and if we are not careful the next generation will have to go through the challenge of more fierce and advanced infections without the defense of antibiotics.
The only viable solution is the rational use of antibiotics. This has to be done starting from industrial level, going down to the individual level.
As conscientious human beings, it’s our duty to use antibiotics only when indicated, in the duration of time it’s indicated and to choose the most appropriate antibiotic to the condition. By avoiding taking unnecessary antibiotics, we will be contributing to saving hundreds of lives tomorrow.
(The writer is a Final Year medical student)



